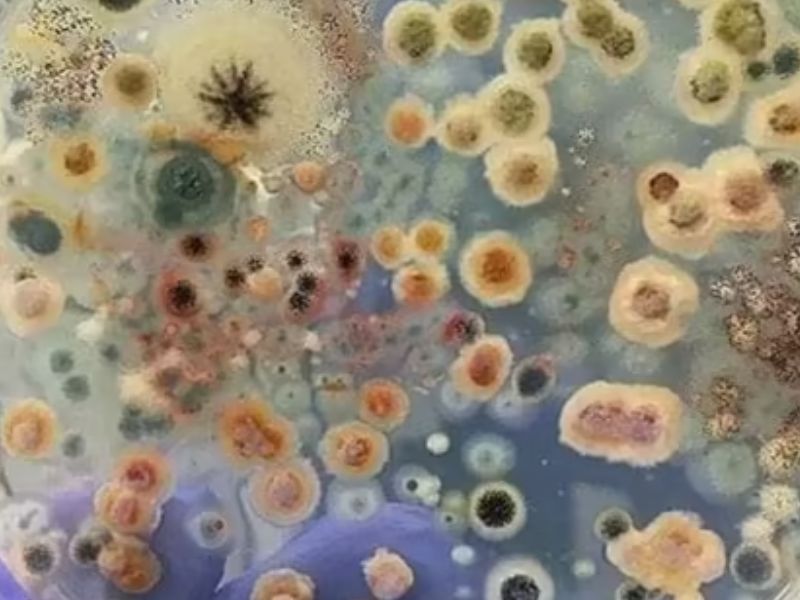
致命真菌爆發 從內到外吞噬宿主

|
 瀏覽:1084 美國出手 轟炸伊朗三處核設施 |
 瀏覽:645 醫生借婦科檢查 20 年性侵 94 名女性 |
 瀏覽:2061 熱氣球空中起火墮地,至少 8 人死亡 |
 瀏覽:312 伊朗核武:特朗普與國家情報總監分歧 |
 瀏覽:4333 馬景濤直播間 後腦着地暈倒 |
 瀏覽:492 姐弟戀情侶爭執 男子掌摑女友被捕 |
 瀏覽:520 新田公路 4 車連環相撞 |
 瀏覽:749 將軍澳突發火警 |
 瀏覽:3956 網傳成都公園發生聚眾淫亂 |
 瀏覽:1053 亞洲成功學大師,最終被判無期 |
 瀏覽:785 操作不當可致死,揭秘高潮針真相 |
瀏覽:933 致命真菌爆發 從內到外吞噬宿主 |
 瀏覽:787 9 名伊朗核科學家,睡夢中被暗殺 |
 瀏覽:1047 發現逆轉糖尿病開關,或根治全球 6 億患者 |
 瀏覽:870 中國留學生,強姦至少 50 名女性 |
◀ 1 2 3 4 5 ... 16 ... 555 556 557 558 559 ▶ |
@ 2019-2026
最後更新:2026-04-16
文章數:8525 / 閱讀量:65143888